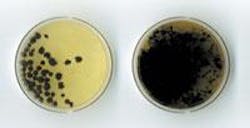
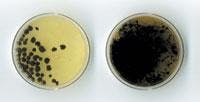

Myths and Misconceptions Regarding Class "A" Sludge
By Joseph H. Herndon
Though confusion still remains among the public regarding the significant differences between Class "B" and Class "A" sludge, the promise of sludge reuse has begun to blossom fully after years of evolution toward the ideal of a totally sustainable, economically sound, environmentally safe, publicly acceptable large-scale waste-to-product cycle.
Along the way, all parties have been guilty of creating "absolutes" that now, in practice, are proving to be nothing more than widely-held misconceptions. Some of these misconceptions, or assumptions, have reached almost mythical proportion and are all to often accepted as common knowledge, without question.
Now, as Class "A" sludge truly begins to find it's place in the fertilizer market, perhaps it is time to explore some of the more common myths and misconceptions that we are "living with" as an industry.
Market Misconception: Class "A" sludge will find its place in the marketplace at the retail level.
In the original vision of sludge going to market, it was always in a beautiful retail-sized bag — similar to a conventional bag of fertilizer — and it was sold in a Home and Garden Store for use in the individual yards and gardens of suburbia. Well, today this of course happens here and there, but on a relatively small scale.
Today, and for the foreseeable future, it is far more likely that newly minted Class "A" sludge will ultimately go — in bulk — to a direct-land-applied agricultural application or to the lawn-care or nursery industry. This may seem like a small distinction, but it makes a giant difference in the form and nature of the "preferred" Class "A" characteristics required by the buyers.
Myths Regarding Form: A pelletized product is always preferred for resale purposes.
For years, it has been thought that the ideal form — cost aside — for dried Class "A" sludge was that of a small pellet approximately 4mm in size. As it turns out, this is an excellent size only for certain applications. In the afore mentioned example of Class "A" sludge being bagged for individual home use, the pellet form provides advantages in handling and in appearance that benefit its marketing.
However, in the much more common direct-land-application uses, the pellet form adds little or no value. In fact, in many direct-land-application uses, the granular form of Class "A" sludge is preferable. This is because the granular form — with its variation from 4mm to 1mm to fines — provides a dramatic increase in surface area, allowing it to deliver nutrients to the soil more quickly.
This variation also enhances the time-release effect of Class "A" sludge, as the size variances of granular sludge provides a natural spread in activation times. For example, the smaller sized fines will completely dissolve shortly after they are introduced to water, while the largest sized particles will dissolve over many months.
Aside from the added costs of producing pellets, there are specific marketing problems that are common to the pelletized form of Class "A" sludge. As you may know, pellets are formed through a series of steps including: mixing, heating, and screening, with fines and smaller particles being recycled through the mixing, heating, and screening cycle, until they reach a specific size. This process naturally creates a layering effect — much like the layers of an onion — which in application can significantly delay the disintegration of the individual pellets. Also, it is possible for binding compounds used in a pelletizing operation to delay the pellets reaction with water.
In combination, these factors of pellet manufacturing can delay pellet disintegration up to 24 months. In specialized applications, such as fertilizer for golf course greens, the resistance to disintegration can be a real detriment. In other applications, such as agricultural soil-building, the particulate form of the Class "A" sludge may be of little or no importance.
The Value Misconception: Class "A" sludge is just as good as chemical fertilizer.
Actually, Class "A" sludge is better than chemical fertilizer in some respects. In addition to the nutrient value, Class "A" sludge provides organic materials that are invaluable to soil building. For this reason, many processors mix Class "A" sludge with chemical fertilizer in agricultural applications.
Digestion related Myths: Sludge must be digested before it is dried.
Digestion has been thought to be essential in the production of marketable Class "A" sludge. This, as it turns out, is not necessarily true.
The reason for the digestion of sludge prior to drying has been to reduce the odor of the end product, both when it is dry and when it is moist. Odor issues are extremely important to individual users, such as homeowners. However, it is of less importance to large agricultural users. This is an especially important issue as the capital cost of digestion equipment is significant — it can mean the difference between being able to proceed into the processing of Class "A" sludge or not for smaller-sized wastewater facilities.
In a recent study, the odor (i.e., bad smell or hedonic tone), intensity of smell, and persistence were compared between undigested and digested Class "A" sludge — both in the dry and moist state.
In this carefully executed study, the undigested sludge garnered a bad smell value of –4.1, while the digested sludge achieved a level of –2.7. In this same study the intensity of the odor varied from 150 for the undigested samples to 45 for the digested samples. Further, the persistence level of the undigested sludge was ranked at –0.45 versus –0.30. The undigested sludge was characterized using the words sour, decay, rancid, and earthy. The digested sludge was characterized using the words earthy, decay, burnt and stale.
When moist (33 percent moisture added), the undigested sludge scored a hedonic tone of –5.7 and digested sludge scored a hedonic tone of –5.6. The moist undigested sludge was described with the words earthy, garbage, sour, and decay. The digested sludge was described with the words garbage, sour, earthy, and burnt. Under these moist conditions, it is easy to see that the samples had near the same characteristics of odor.
It should be noted that when the samples were inoculated with soil that differences again surfaced. After 24 hours with soil, the undigested sludge registered a hedonic tone of –6.3, and the digested sludge registered a hedonic tone of –5.0. The undigested sludge had a persistence level of –0.46, and the digested sludge had a persistence level of –0.31. At this point, the undigested sludge was described with the words earthy, rancid, garbage, and sour. The digested sludge, likewise, was described with the words vegetable, sour, burnt, and earthy.
The results of this study indicate that the difference in odor, intensity, and persistence between undigested and digested Class "A" sludge is measurable, but in some cases by quite a small margin. Does this mean that all sludge should be digested prior to drying? Probably not. However, this study along with direct field experience indicates that digestion is not the "essential" that it was once thought to be.
It is a fact that Class "A" sludge — in all its forms — is a large part of the real vision of the future.
As with most things, experience has shown that "absolutes" are soon exposed and that when planning a Class "A" sludge production facility there are no automatic answers. Certainly, it is important to consider the "real" markets for the product — which exist virtually everywhere — and to make the process decisions based on the specific needs of an identified end-user or buyer.
It may, in fact, not be necessary to go to the expense of palletizing your Class "A" product — it could even turnout to be a detriment for specific end-users. It may, in fact, not be necessary to add digestion — if these facilities do not already exist — to your process to successfully market your Class "A" product. It may, in fact, be true that you can move to the marketing of a Class "A" product sooner — and at less expense — than you may think.
About the Author
Joseph H. Herndon has more than 30 years of experience in the water and wastewater industry and has worked extensively with fertilizer brokers and landowners in the Southeastern United States.